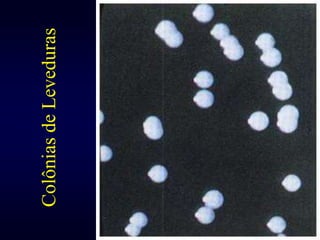
16Colônias de Leveduras

O documento descreve propriedades gerais dos fungos, incluindo sua estrutura celular, tipos (leveduras, filamentosos, dimórficos), reprodução (sexuada e assexuada), classificação, e micoses causadas (superficiais, cutâneas, profundas, oportunistas). Aborda características como nutrição, distribuição, doenças causadas e importância ecológica.